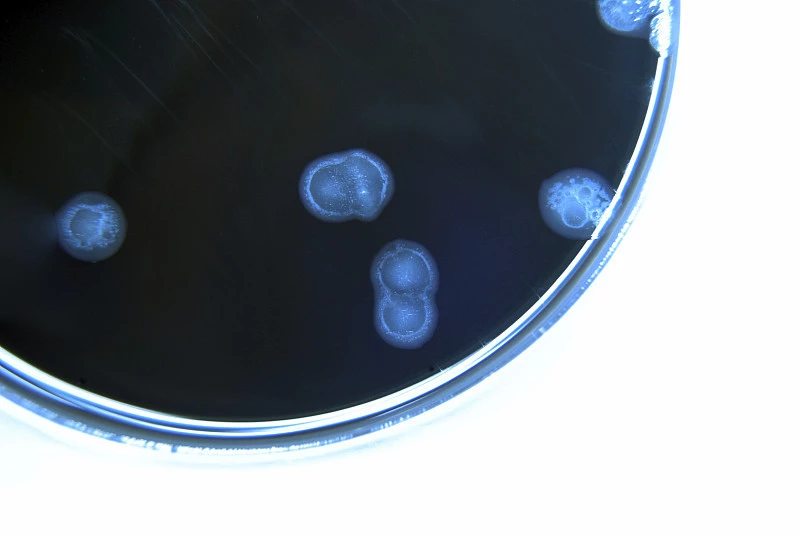

办证所需的条件
服务指南
一、受理
申请机构登陆药物非临床研究质量管理规范认证电子申请系统,在线填报申请书和申请资料。电子申请完成后将纸质资料寄至国家药品监督管理局食品药品审核查验中心受理窗口,5个工作日内进行形式审查,并作出受理决定。
二、资料审查与现场检查
1.国家药品监督管理局食品药品审核查验中心进行资料审查和现场检查。
2.国家药品监督管理局食品药品审核查验中心在现场检查结束后完成检查结果的分析和汇总,向国家药品监督管理局药品注册管理司(中药民族药监督管理司)报送现场检查审核件及相关资料。
三、审查及决定
国家药品监督管理局在20个工作日内作出审批决定。对通过GLP认证的,发给GLP认证批件,并通过国家药品监督管理局网站予以公告。

我们所能提供的服务





相关文章

18576401396
18576401396 







